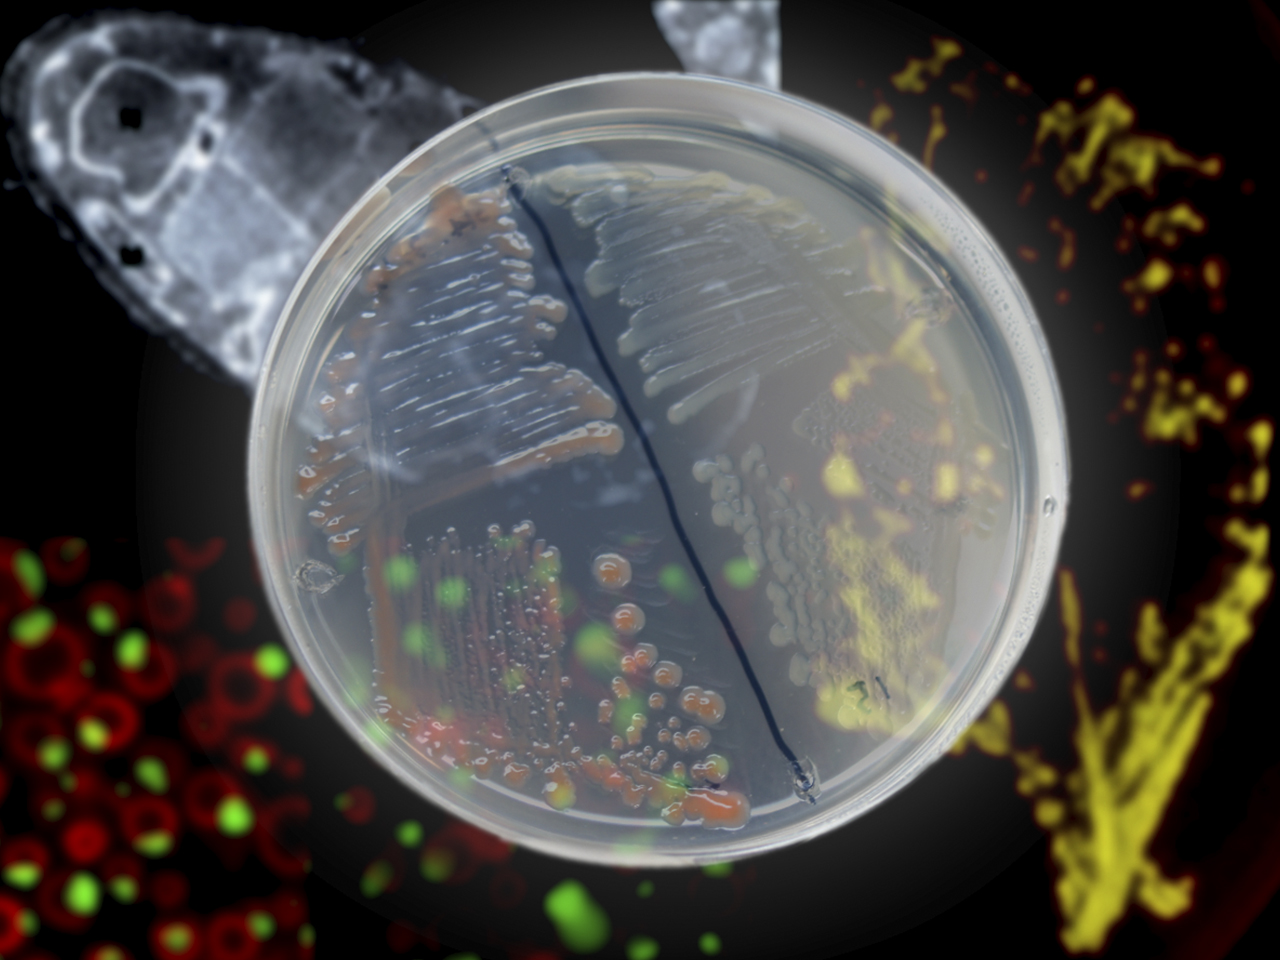

現在、温暖化や化石資源の枯渇、人口爆発による食糧難など地球規模の課題が持ち上がっています。そのため、自然環境への負荷を小さくしながら食糧やエネルギーを確保する持続可能型社会の構築が求められています。このような課題を解決していくためには、さまざまな生物が持つ生命機能の共通性・多様性を解明し、高度に利用することが重要となります。したがって、様々な専門分野の研究者の協力・連携が必要不可欠です。
応用生命科学専攻では、化学と生物を軸にして基礎および応用研究を展開する農芸化学という学問領域を中心に据え、学際的かつ国際的な研究教育活動を推進しています。具体的には、物理化学、有機化学、生化学、分子生物学、細胞生理学を始めとした多角的なアプローチを駆使し、微生物や植物、動物、また異種生物間で生じる相互作用など様々な現象について分子レベルで理解することを目指しています。さらに、新たな発見を基に応用研究に発展させ、社会の発展に貢献することも本専攻の重要な役割です。独自の視点で生命現象を深く理解して新しい原理を導き出し、それを発展させ独創的な技術開発をなし得る人材、日本に留まらず世界の産官学を支える人材の育成を行っています。

応用生命科学専攻は、歴史的には農芸化学分野から発展してきました。私たちは、生命、食料、環境について、「生物と化学」に関連した事象を基礎から応用まではば広く研究し、その研究成果を活かして人類の生活・福祉の向上に役立つように心がけています。
応用生命科学専攻は16分野と1寄附講座から成っており、微生物、植物、昆虫、動物とさまざまな生物を研究対象としています。それらの生命現象および生物機能について、物理化学、有機化学、生化学、分子生物学、細胞生理学、構造生物学などに基づき、分子や細胞のレベルで基礎的に解明しています。さらに、これらの基礎研究の成果を基にして、農業生産、発酵・食品・化学工業、環境保全などの実社会で生じるさまざまな課題を解明し、環境に優しい新しいバイオテクノロジーの創出をめざしています。とくに、現代社会では自然環境を維持しながら食糧・エネルギーを確保し、生活の質を向上させることが求められています。この困難な課題を解決するためには、生物が持つ能力をうまく利用することがますます重要になると予想されています。私たちは、大学院での研究・教育を通じて、生命現象の深い理解に立脚した独創的な研究を行い、さらにそれに基づいた革新的な技術を開発できる研究者・技術者の養成をめざしています。本学は創立以来築いてきた自由な学風を重んじており、大学院教育においても様々な学問領域を自発的に学び、研究課題を自ら設定できる高い意識を持つ研究者・技術者になってほしいと考えています。また、本学のシンボル「くすのき(楠)」は、長い時間をかけて着実に大木へと生長します。このことから、ゆっくりではあるものの堅実に成長し、大成する学問のことを「楠学問」と呼んでいます。既存の価値観にとらわれず、長期的なビジョンを描いて魅力ある学問を構築することをめざしています。
応用生命科学専攻では、応用生命科学科(学部)に比べて定員が大幅に増加し、これまでの実績として毎年20名程度外部入学者を受け入れています。各分野では、さまざまな教育・研究を行っており、他大学・他学部など応用生命科学科の卒業生以外の大学院生も学部までの経験を活かしながら独自の研究を進めています。広い視野で深く考えながら、思い切り実験・研究を楽しみ、研究者・技術者として大きく成長して頂きたいと考えています。
興味のある方は,まずは気軽に研究室を訪問してみてください。是非一緒に,おもろい研究に挑戦しましょう。
京都大学 農学研究科
応用生命科学専攻 専攻長
白井 理

本専攻に在籍する教員の研究内容や経歴、目標、メッセージをお届けします。
「植物細胞壁 = バイオマス」の成り立ちを調べ、コントロールする
老化に伴う疾患の理解と食による健康長寿社会の実現
植物ホルモンは人類を救う
多細胞生物における細胞の運命決定の仕組みに迫る
| 講座名 | 研究室 | 教授 | 准教授 | 助教 |
|---|---|---|---|---|
| 応用生化学講座 | 細胞生化学 | 木岡 紀幸 | 木村 泰久 | 黒田 美都 永田 紅 (特任助教) |
| 生体高分子化学 | 菅瀨 謙治 | 黒田 浩一 | 青木 航 | |
| 生物調節化学 | 宮川 恒 | 宮下 正弘 | - | |
| 化学生態学 | 森 直樹 | 小野 肇 | 吉永 直子 | |
| 分子細胞科学講座 | 植物栄養学 | 伊福 健太郎 | 小林 優 | 落合 久美子 |
| エネルギー変換細胞学 | 井上 善晴 | - | 野村 亘 (特任助教) | |
| 応用微生物学講座 | 発酵生理及び醸造学 | 小川 順 | 岸野 重信 | 安藤 晃規 |
| 制御発酵学 | 阪井 康能 | 由里本 博也 | 白石 晃將 | |
| 生物機能化学講座 | 生体機能化学 | 白井 理 | - | 北隅 優希 宋和 慶盛 |
| 生物機能制御化学 | 三芳 秀人 | 村井 正俊 | 桝谷 貴洋 | |
| 応用構造生物学 | - | - | 水谷 公彦 | |
| 生体分子機能部門 (化学研究所) |
分子生体触媒化学 | 山口 信次郎 | - | 増口 潔 |
| 分子微生物科学 | 栗原 達夫 | 川本 純 | 小川 拓哉 | |
| 木質生命科学部門 (生存圏研究所) |
森林圏遺伝子統御学 | 矢崎 一史 | 杉山 暁史 | 棟方 涼介 |
| 森林代謝機能化学 | 梅澤 俊明 | 飛松 裕基 | - | |
| 木質バイオマス変換化学 | 渡邊 隆司 | - | 渡邊 崇人 西村 裕志 |
|
| 寄付講座 (農学研究科) |
産業微生物学 | 上田 誠 (客員教授) |
原 良太郎 (特定准教授) |
竹内 道樹 (特定助教) |
修士課程・博士課程の修了生の多様なキャリアパスを紹介します。(2022年9月)
『最後』の学生生活を、『最高』の環境、仲間と共に…。
多角的な視点で農業の未来を切り拓く
予定通りになんていきません
咲く場所は自分で選べるということ(植物と違って)